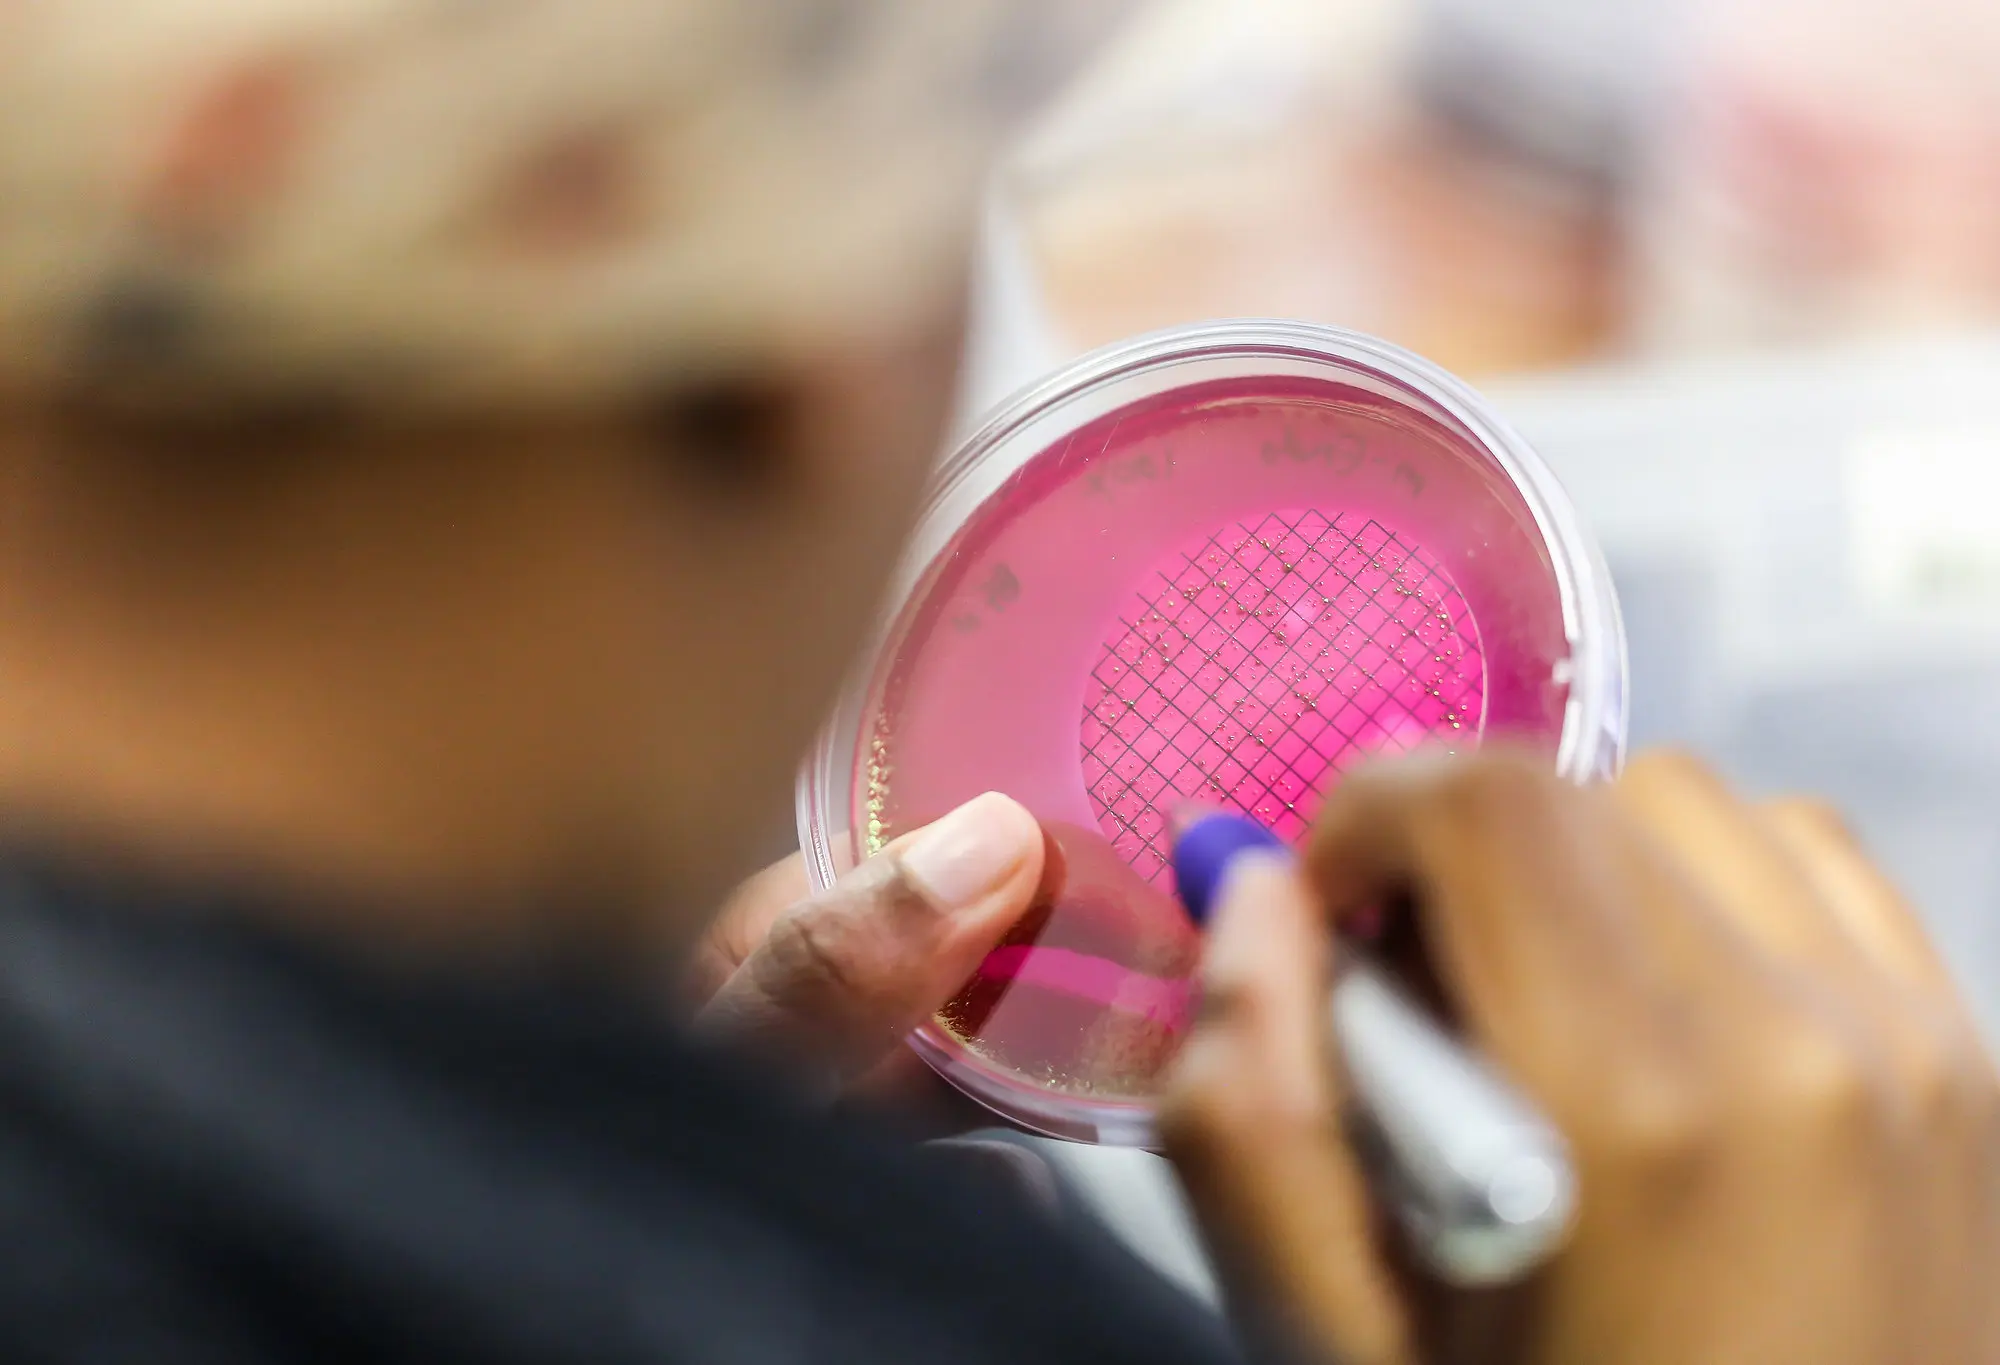
ScienceGeist Debatten zur Wissenschaftspolitik

ScienceGeist: Debatten zur Wissenschaftspolitik kompakt und international
Das Online-Angebot bietet einen kuratierten Überblick über aktuelle Beiträge zur Wissenschaftspolitik und unterstützt damit Forschende und Interessierte bei der schnellen Orientierung im Themenfeld.
Wie wirken wissenschaftliche Erkenntnisse auf politische Entscheidungen – und umgekehrt? Welche Reformen braucht das Publikationssystem, damit Forschung verlässlich bleibt? Wie beeinflussen Evaluationen die Wissenschaft? Und was bedeutet all das für die Zukunft von Forschung und Politik?
ScienceGeist greift solche Fragen auf und kuratiert täglich Beiträge aus internationalen Medien, Blogs und Fachzeitschriften. Das Angebot bietet der Forschungsgemeinschaft einen Überblick über aktuelle Diskussionen zu Themen wie Peer-Review, Open Science, Forschungsintegrität, Karrieren oder Reproduzierbarkeit.
Die Online-Datenbank umfasst zurzeit rund 14900 Beiträge, lässt sich gezielt durchsuchen und reicht bis 2013 zurück. Interessierte können eigene Artikelvorschläge einreichen. Alle zwei Wochen fasst die Redaktion im Newsletter die wichtigsten Beiträge zusammen – ausschliesslich auf Englisch, der gemeinsamen Sprache der Wissenschaft. Obwohl die Inhalte von SNF-Mitarbeitenden kuratiert werden, spiegeln die geteilten Artikel nicht zwingend die Haltung des SNF wider.